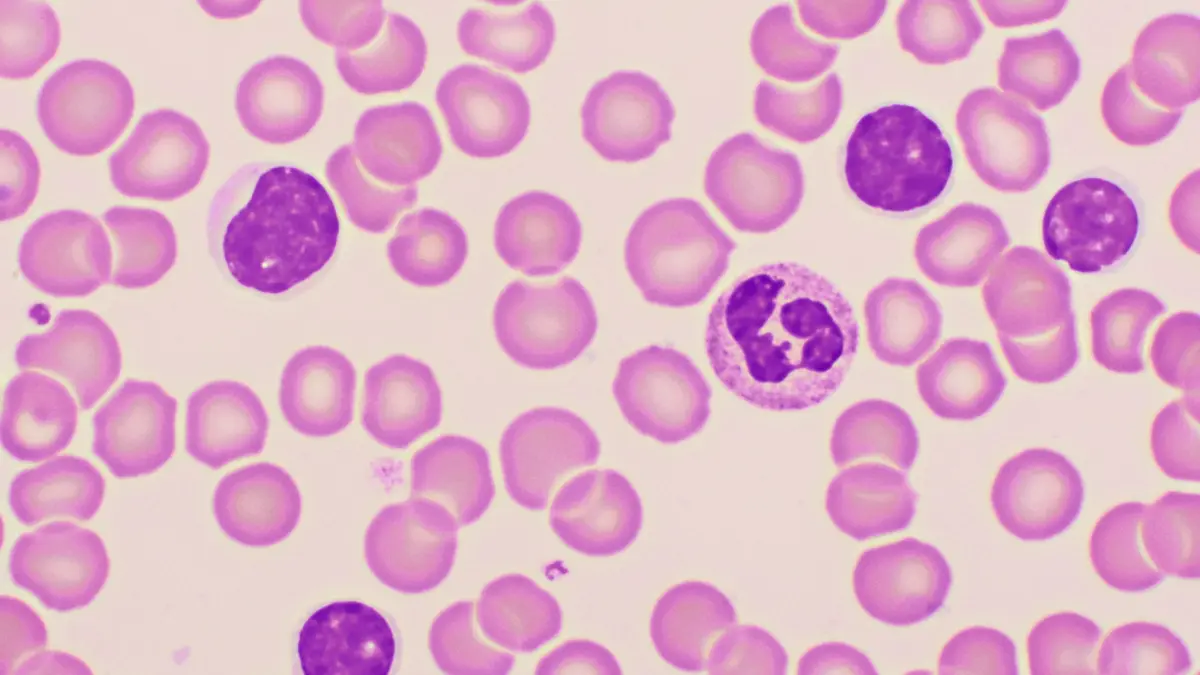

Die chronische lymphatische Leukämie ist die häufigste leukämische Erkrankung der westlichen Welt mit einer Inzidenz von 4,2 pro 100.000 Einwohnern. Meist werden Patienten in frühen, asymptomatischen Krankheitsstadien diagnostiziert in denen „watch & wait“ das Standardbehandlungskonzept ist. Seit der Einführung von zielgerichteten Therapien spielt die Chemoimmuntherapie sowohl in der Erstlinie- als auch in der Rezidivtherapie keine Rolle mehr. Der folgende Artikel soll die verschiedenen Therapiekonzepte, Herausforderungen, sowie die neuesten Entwicklungen bei der Behandlung von Patienten mit CLL beleuchten.
Aktuell, informativ und praxisrelevant
Aktuelle Themen, spannende Expertentalks und Einblicke in Forschung, Praxis und Trends. Hören Sie jetzt die aktuelle Folge des mgo medizin Podcasts!
NEWSLETTER - Das Beste aus der Branche!
Melden Sie sich jetzt für unseren Newsletter an und erhalten Sie regelmäßig aktuelle Informationen, spannende Fachartikel und exklusive Angebote aus der Medizin - direkt in Ihr Postfach
Die Medizinwelt digital erleben!
Lesen Sie alle Ausgaben unserer Fachzeitschriften im ePaper-Archiv – digital, komfortabel und jederzeit verfügbar für Ihr medizinisches Fachwissen auf Abruf.